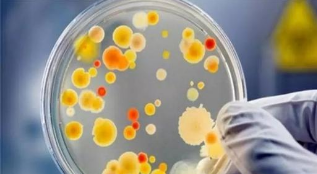

- 【推薦】大家都在看
- 聯系我們Contact us
-
- 環檢檢測
- 熱線:
- 手機:13819451621(微信同號)
- 地址:杭州市蕭山區新塘科創園3-418室
時間:2020-10-29 作者:環檢檢測
微生物檢測事關人類健康和環境安全,涉及多個行業、多個領域,在實驗室檢測中具有重要地位。以下就是我們日常生活中常遇到的關于微生物檢測的常見問題做一個詳細的解答,有興趣的朋友可以一起來了解。
一、金黃色葡萄菌檢測第二法,從典型菌落中任選5個,是從一個平行樣中選5個還是5個平行樣加起來選5個?
答案:從符合計數范圍的稀釋度三個平行樣中任選五個做血漿凝固酶試驗。
二、微生物回收采用涂布法時,試驗組1ml含菌量不大于100cfu.涂布時取供試液0.2ml,含菌量會不會太少,不利于計數?
答案:涂布法回收準備工作是取隔夜培養物0.2ml,進行梯度稀釋,大概稀釋到10的6次方可以達到100cfu/ml,然后分別取0.3,0.3,0.4ml進行涂布,也可以前后兩個梯度均進行334涂布。
三、哪些奶粉需要檢測阪崎腸桿菌,依據的標準是什么?
答案:一段嬰幼兒奶粉都需要,企業為保證其質量,因此會制定內部質量控制標準或規定對其相關原輔料,包裝材料以及直接接觸面等進行檢測,當然包括奶粉量勺等。具體依照GB10765-2010.
四、在進行煮沸滅菌培養基配置過程中如何避免液體噴灑出來被燙傷的情況,有什么好的滅菌方法,又可以有效防護?
答案:選擇口徑大的三角燒瓶,培養基以不超過三角燒瓶容積的1/3為宜,電爐上加蓋石棉網,帶上高溫手套,專人看守防止爆沸。
五、霉菌檢測中PDA和孟加拉紅培養基,效果一樣嗎?有沒有哪種更適合哪一類?
答案:PDA中氯霉素可以抑制細菌生長,孟加拉紅不僅含有氯霉素抑制細菌生長,并且抑制繁殖較快的霉菌菌落的大小和高度,還作為著色劑,便于菌落觀察。
六、食品微生物檢驗大腸菌群和沙門氏菌要求調節PH,可以調整樣品原液嗎?如果調樣品原液會對結果有影響嗎?有些做原液,如果調整樣品勻液,原液也得調整嗎?
答案:需要調節PH的樣品種類不多,大部分食品ph在6-8之間。PH調節液體從原液開始調整;固體從十倍稀釋度調節。除了個別樣品(食醋等)調節PH需要較多試劑,其他樣品僅需微量,對微生物檢測來說影響很小。
以上六個問題是微生物檢測中常見問題,希望能夠幫助到大家。

環檢CMA檢測實驗室擁有專業的技術團隊,配備各類先進的檢測儀器,可以滿足絕大部分污染檢測需求。杭州環檢檢測科技有限公司是一家專業從事第三方檢驗檢測技術服務的高新技術企業,業務范圍輻射整個中國。本中心主要檢測服務項目為專業的室內污染檢測及人造材料污染物釋放量和含量檢測,涵蓋甲醛檢測、氨氣檢測、氡氣檢測、TVOC檢測、苯系物檢測等等。
- 2022-06-16甲醛中毒會有哪些癥狀?新房提早檢測健康入住
- 2022-06-06如何科學有效的除甲醛?新房裝修甲醛檢測的重要性
- 2022-05-30甲醛檢測數據真實嗎 新房含甲醛板材你知道幾種?
- 2022-05-25室內空氣污染與健康息息相關,你家有進行裝修污染檢測嗎?
- 2022-05-23冬季需要做甲醛檢測嗎又該如何應對甲醛問題
- 2022-04-23室內空氣污染每天至死304人!室內甲醛檢測已成當務之急
- 2022-04-23怎么知道室內甲醛是否超標?又怎么進行室內空氣檢測?
- 2022-04-13家庭室內甲醛檢測時,該采用哪種國家檢測標準?
- 2022-03-0990%的家庭不懂室內空氣檢測,該怎樣選擇檢測機構?
- 2022-03-09老人咳嗽不止殊不知是甲醛超標引起的
- 2022-02-28裝修污染太可怕,別不檢測就搬進新家!
- 2022-02-28為什么兒童甲醛中毒數量會增加?室內甲醛檢測家長注意了!



